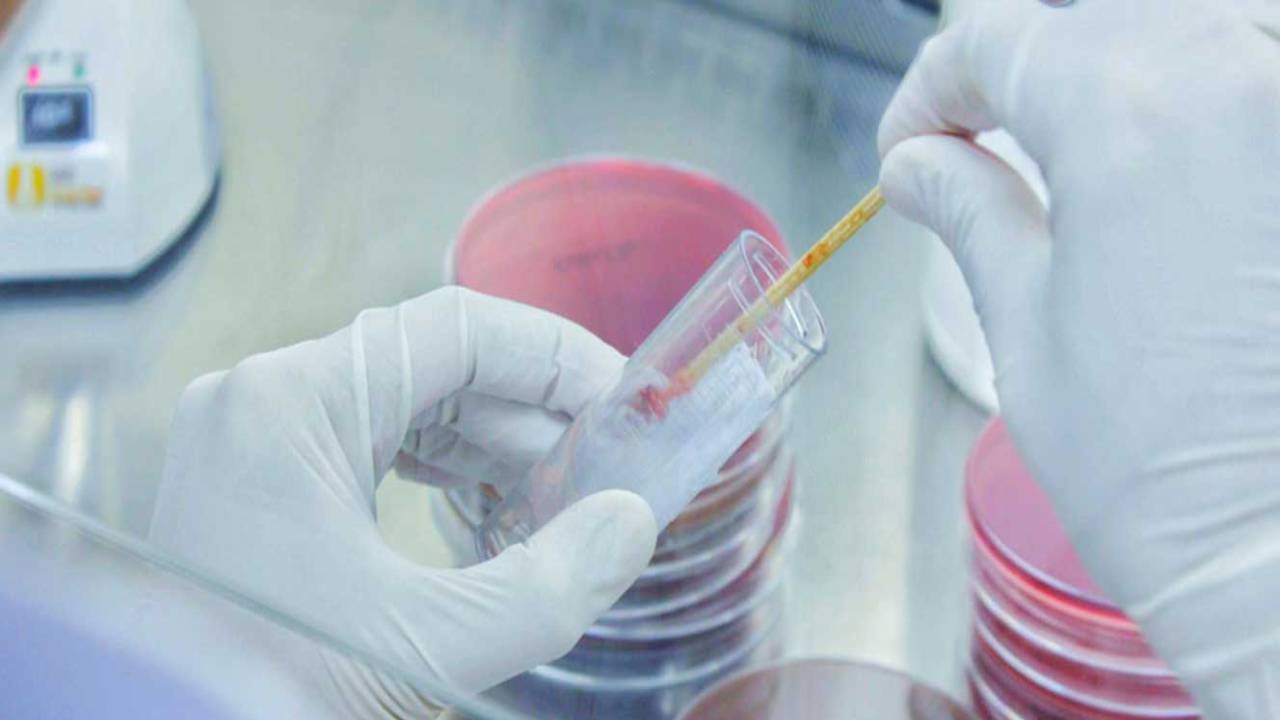

En Keskin Balgam Söktürücü: 5 Adımda Genizdeki Balgamdan Nasıl Kurtulunur?
Mevsim geçişlerinde en keskin balgam söktürücü, pek çok kişi tarafından araştırılan konu olmuştur. Balgam, solunum sistemindeki hava yollarında üretilen ve öksürük ile dışarı atılan yapışkan bir sıvıdır. Çeşitli sebeplerle şifayı kapan veya sigara içen kişilerde öksürük ve balgam oluşumu sıklıkla görülmektedir.
Hayat kalitesini düşüren balgam ve beraberinde getirdiği öksürük ciddi huzursuzluk vermektedir. Peki balgam nasıl oluşur? En keskin balgam söktürücü nedir? İşte oh dedirtecek ve akciğerlerinizi rahatlatacak altın değerinde bilgiler!
Balgam Nasıl Oluşur?
Balgam, mukus adı verilen bir salgıdan oluşur. Mukus, burun, boğaz, bronşlar ve akciğerler gibi solunum yolunun iç yüzeyini kaplayan hücreler tarafından üretilir. Balgamın ana işlevi, solunum yolunu nemlendirmek, korumak ve temizlemektir.
Solunum yolunda bulunan kirleticiler, toz, mikroplar veya diğer yabancı maddelerle temas ettiğinde, vücut bu maddeleri uzaklaştırmak için balgam üretir. Balgam, bu yabancı maddeleri yakalar ve öksürük refleksiyle dışarı atılmasını sağlar.
Balgamın rengi, kıvamı ve miktarı, altta yatan bir duruma bağlı olarak değişebilir. Örneğin, soğuk algınlığı, grip, sinüzit veya bronşit gibi solunum yolu enfeksiyonları balgam üretimini artırabilir. Balgamın normalden farklı renk, koku veya kıvama sahip olması, şiddetli öksürük, nefes darlığı veya diğer rahatsız edici semptomlar eşlik ediyorsa, doktora danışmak önemlidir.
Peki, en keskin balgam söktürücü nedir? Genizdeki balgamdan nasıl kurtuluruz?

En Keskin Balgam Söktürücü: 5 Adımda Genizdeki Balgam Nasıl Atılır?
En keskin balgam söktürücü ilaçlara başvurmak yerine önce genizde biriken balgamı atmak için aşağıdaki adımları deneyebilirsiniz:
- Su için: Bol su içmek geniz sekresyonlarının seyrelmesine ve daha kolay atılmasına yardımcı olabilir.
- Buhar inhalasyonu: Sıcak su dolu bir kabın üzerine eğilin ve başınızı bir havluyla örtün. Bu şekilde teneffüs ederek buharı soluyun. Bu yöntem, genizdeki mukusu yumuşatarak ve çözerek atılmasına yardımcı olabilir.
- Tuzlu suyla gargara yapın: Bir bardak ılık suya 1 çay kaşığı tuz ekleyin ve karıştırın. Bu tuzlu su ile gargara yapmak, geniz bölgesindeki balgamı gevşetmeye ve atmanıza yardımcı olabilir.
- Nemlendirici kullanın: Gece yatarken nemlendirici bir hava nemlendirici veya buhar makinesi kullanmak, genizdeki mukusu yumuşatarak atılmasını kolaylaştırabilir.
- Öksürük ilacı veya balgam söktürücü ilaçlar: Eğer balgam çok yoğun veya rahatsız edici bir durumdaysa, doktorunuzun önerisiyle öksürük ilacı veya balgam söktürücü ilaçlar kullanabilirsiniz. Doktor, altta yatan bir sorunun varlığını değerlendirebilir ve uygun tedavi en keskin balgam söktürücü yöntemlerini önerebilir.
En İyi Balgam Söktürücü Bitki Nelerdir?
En keskin balgam söktürücüler arasında bitkilerde yerini almıştır. Bu bitkilerin çaylarını hazırlayarak veya bazılarını yemeklere baharat olarak ekleyerek balgam söktürücü etkilerinden faydalanabilirsiniz. Ancak, her bitkinin etkisi kişiden kişiye değişebilir ve bazı kişilerde alerjik reaksiyonlara neden olabilir. En keskin balgam söktürücü bitkiler arasında şunlar bulunabilir:

|
Bitki Adı |
Amacı ve kullanım şekli |
|
Adaçayı (Thymus vulgaris): |
Balgamın çözülmesine ve solunum yolunun açılmasına yardımcı olabilir. Demleyerek çay olarak tüketebilirsiniz. |
|
Kekik (Thymus serpyllum): |
Mukolitik özelliklere sahip bir bitkidir ve balgamın incelmesine yardımcı olabilir. Bir bardak kaynar suya bir çay kaşığı kuru nane veya taze nane yaprakları ekleyin. 10-15 dakika demlemeye bıraktıktan sonra süzerek içebilirsiniz veya baharat olarak yemeklerde kullanabilirsiniz. |
|
Zencefil (Zingiber officinale): |
Anti-enflamatuar ve en keskin balgam söktürücü özelliğine sahiptir. Balgamın seyrelmesine ve solunum yolunun rahatlamasına yardımcı olabilir. Bir dilim taze zencefili kaynar suya ekleyin. Ardından süzerek içebilirsiniz. Bal veya limon suyu ekleyerek tatlandırabilirsiniz veya yemeklere ekleyebilirsiniz. |
|
Nane (Mentha piperita): |
Nane, balgam söktürücü ve rahatlatıcı etkilere sahiptir. Nane yağı inhalasyonu yaparak faydalanabilirsiniz veya demleyebilirsiniz. |
|
Papatya (Matricaria chamomilla): |
Papatya, anti-enflamatuar ve balgam söktürücü özelliklere sahiptir. Papatya bitki çayı olarak tüketebilirsiniz. |
Evde Uygulanabilir En Keskin Balgam Söktürücü|Bal ve Limon Balgam Söktürücü Tarifi
Bal, boğazı yumuşatırken limon ise balgamın incelmesine yardımcı olabilir. Evde deneyebileceğiniz en keskin balgam söktürücü, bal ve limon karışımını kullanarak basit bir tarif:

Malzemeler:
1 yemek kaşığı bal + 1\2 limonun suyu
Yapılışı:
Bir kâseye 1 yemek kaşığı balı ekleyin. Yarım limonun suyunu sıkarak balın üzerine ekleyin. Karışımı iyice karıştırın. Bu karışımı yavaşça yutabilirsiniz. Ancak, herkesin vücut tepkileri farklı olduğu için bu yöntemin etkisi kişiden kişiye değişebilir. Unutmayın, bu doğal yöntemler semptomları hafifletebilir ancak altta yatan bir sağlık sorununu tedavi etmez.
En Keskin Balgam Söktürücü İlaç Nedir?
En keskin balgam söktürücü ilaç, genellikle doktor tarafından reçete edilen ilaçlardır. Ancak, bazı reçetesiz satılan ilaçlar da etkili olabilir. İlaç seçimi, semptomlarınıza, sağlık durumunuza ve mevcut ilaçlarınıza bağlı olarak değişebilir. En keskin balgam söktürücü ilaç örnek vermek gerekirse şu türler bulunabilir:
- Mukolitikler: Balgamın incelmesine yardımcı olan ilaçlardır. Örnek olarak, guaifenesin gibi mukolitik ilaçlar kullanılabilir.
- Ekspektoranlar: Balgamın çıkmasını kolaylaştıran ilaçlardır. Örnek olarak, bromheksin veya asetilsistein içeren ilaçlar kullanılabilir.
- Bronkodilatörler: Balgamın hava yollarından daha rahat geçmesini sağlayan ilaçlardır. Örnek olarak, salbutamol veya ipratropium bromid gibi bronkodilatörler kullanılabilir.
Viks Balgam Söktürücü İlaç Nasıl Uygulanır?
Vicks, en keskin balgam söktürücü olarak kullanılan popüler ilaçlar arasında yer almaktadır. Vicks'in içerdiği mentol ve kamfer gibi bileşenler, solunum yolunu rahatlatmaya ve balgamın çıkmasını kolaylaştırmaya yardımcı olabilir. Vicks Vaporub adlı ürün, göğüs ve sırt bölgesine masaj yapmak, göğüs ve sırt bölgesini ısıtır ve buharın etkisini artırabilir.
Buhar inhalasyonu için ise, bir kâse sıcak suya biraz Vicks Vaporub ekleyin, başınızı havluyla örtün ve buharı soluyun. Bu, solunum yolunun açılmasına ve balgamın çıkmasına yardımcı olabilir.
En Keskin Balgam Söktürücü: Suda Eriyen Balgam Söktürücü İlaç
Suda eriyen balgam söktürücü ilaçlar genellikle efervesan tablet veya toz formunda bulunur. Bu tür ilaçlar, suya atıldığında çözünerek içilebilir bir solüsyon oluştururlar. İşte en keskin balgam söktürücü bazı örnekler:
- N-acetylcysteine (N-asetilsistein): Balgamın seyrelmesine yardımcı olan bir mukolitik ilaçtır. Efervesan tablet veya toz formunda bulunabilir.
- Bromhexine: Balgamın çıkmasını kolaylaştıran bir ekspektoran ilaçtır. Suda eriyen tablet veya toz formunda bulunabilir.
- Guaifenesin: Balgamın incelmesine ve çıkmasına yardımcı olan bir mukolitik ilaçtır. Efervesan tablet veya toz formunda bulunabilir.
Sigara İçenler İçin Balgam Söktürücü İlaç Nedir?
Sigara içenler için en keskin balgam söktürücü nedir? sorunu sıkça görülür. Sigara dumanı, solunum yolunda tahrişe ve iltihaba neden olabilir, bu da balgam üretimini artırır. Sigara içenler için en keskin balgam söktürücü yöntem, sigarayı bırakmaktır. Sigarayı bırakma sürecinde destek almak için doktorunuza veya sigarayı bırakma programlarına başvurabilirsiniz.
Bunun yanı sıra, sigara içenler için tavsiye edilen doğal yöntemler:
- Bol su içmek: Balgamın seyrelmesine yardımcı olur.
- Nemli ortamda bulunmak: Evde bir hava nemlendirici kullanmak veya duş almak gibi nemli ortamlarda bulunmak, solunum yolunun nemlenmesine ve balgamın daha kolay çıkmasına yardımcı olabilir.
- Sağlıklı beslenme: Anti-enflamatuar özelliklere sahip gıdaları tüketmek, solunum yollarındaki iltihabı azaltabilir. Bu gıdalar arasında yeşil yapraklı sebzeler, meyveler, zencefil, sarımsak ve balık gibi omega-3 yağ asitleri içeren besinler bulunur.
- Egzersiz yapmak: Hafif egzersizler, solunum yolunu açabilir ve balgamın çıkmasını kolaylaştırabilir.




Yazılan yorumlar hiçbir şekilde Saglikmanset.com’un görüş ve düşüncelerine ait değildir. Yorumlar, yazan kişiyi bağlayıcı niteliktedir.